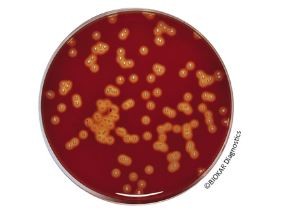
Tryptone-Soy Agar (Blood Agar base)

Rotary Evaporator Package
Price range: $19,902.32 through $30,008.78
MANUFACTURER: SH-SCIENTIFIC
CAT NO: RE-PK-5L|RE-PK-20L|RE-PK-50L
- Description
- Size Guide
- Additional information
- SPECIFICATION
- Vendor Info
- More Products
Additional information
| Rotary Evaporator Package | Rotary Evaporator, cold trap bath(-40°C), vacuum pump, chiller, Rotary Evaporator, cold trap bath((-40°C), vacuum pump, chiller, Rotary Evaporator, cold trap bath, vacuum pump, chiller |
|---|
| Rotary Evaporator | |
| Cold Trap Bath | SH-WB-5GDR (-40℃ or -80℃) |
| Vacuum Pump | 2044-2047 |
| Chiller | SH-WB-12CDR |
| Model | Bath Capacity |
| SH-WB-12CDR | 12.5L (-40℃) |
| SH-WB-20CDR | 20L (-40℃) |
| SH-WB-40CDR | 40L (-40℃) |
| Model | Pump Speed |
| 2044 | 35L/min |
| 2047 | 70L/min |
| Model | Temp Range |
| SH-WB-5GDR(-40℃) | -40℃(-40℉) ~ -20℃(-4℉) |
| SH-WB-5GDR(-80℃) | -80℃(-112℉) ~ -60℃(-76℉) |